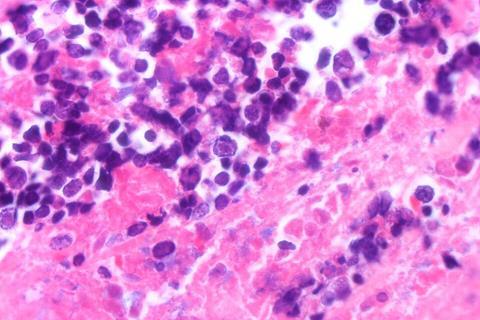

A class of antivirals called Pin1 inhibitors could reduce or stop outbreaks of herpes simplex virus 1 (HSV-1), the common infection behind oral herpes, according to new research published in Antiviral Research on July 25.
HSV-1 causes sores around the mouth, commonly called cold sores or fever blisters. Most people are infected with HSV-1 in childhood, and between 50% and 90% of people worldwide have HSV-1. After the initial infection, HSV-1 remains in the body and can reactivate throughout a person’s life. While HSV-1 infections are usually mild, they can be serious and even deadly for people with suppressed immune systems. Finding new, more effective antivirals for this common illness is essential.
READ MORE: Herpes virus plays interior designer with human DNA
READ MORE: Herpes virus might drive Alzheimer’s pathology, study suggests
Researchers focused on an enzyme called peptidyl-prolyl cis-trans isomerase NIMA-interacting 1, or Pin1, that regulates protein stability, function, and cellular structure. When this enzyme is dysregulated, it can play a role in a variety of conditions, including obesity, cancer, heart failure, and more. Viruses, such as cytomegalovirus (CMV) and SARS-CoV-2, are known to affect Pin1, and Pin1 inhibitors have been developed to reduce the impact of these viruses.
Because HSV-infected cells over-express Pin1, researchers wanted to know if Pin1 inhibitors could also be used to treat HSV-1. “This study revealed that the host factor Pin1 is a crucial therapeutic target for the proliferation of HSV-1. Pin1 inhibitors potently suppress HSV-1 replication at low concentrations,” said Takemasa Sakaguchi, a professor at the Graduate School of Biomedical and Health Sciences at Hiroshima University in Hiroshima, Japan.
Replication halted
In laboratory tests, the Pin1 inhibitor H-77 and the four newly developed Pin1 inhibitors successfully stopped the replication of HSV-1. VeroE6 cells, derived from the kidney of an African green monkey and commonly used in virology research, were infected with HSV-1 and cultured in the presence of different amounts of a Pin1 inhibitor. As the amount of the inhibitor increased, the effects of HSV-1 on the cells became less pronounced and completely disappeared at 1 μM. They also found that any viral particles released from the treated cells were non-infectious.
The most important finding of this study is how Pin1 inhibitors affect cell structures to prevent the virus from escaping. They do this by stabilizing nuclear membrane structure, physically trapping the virus in the cell nucleus.
“The nuclear lamina initially functions as a ‘barrier’ when nucleocapsids of progeny viruses, that replicate within the nucleus, bud from the nuclear membrane. Pin1 overexpressed by the virus removes this barrier. However, through the action of the Pin1 inhibitor H-77, this barrier is rather reinforced, forming a thick and robust lamina layer. This demonstrates that H-77 transforms the nuclear lamina into an ‘impregnable defensive wall,’ physically blocking the escape of viruses from the nucleus of the cell,” said Sakaguchi.
Host-directed therapeutics
Looking ahead, researchers will continue to evaluate the effectiveness of Pin1 inhibitors to treat HSV-1. They will also research how Pin1 inhibitors could be used to treat other viruses.
“The ultimate goal for the future is to aim for the clinical application of Pin1 inhibitors as ‘host-directed therapeutics,’ which are less likely to cause drug resistance. To achieve this, we will first evaluate their efficacy against diverse viruses to clarify the treatable range. Simultaneously, research to optimize the compound structure is essential for creating more potent and selective drugs,” said Sakaguchi.
Other contributors include Abeer Mohamed Abdelfattah Elsayed, Miuko Kurose, Akifumi Higashiura, Akima Yamamoto, Toshihito Nomura, Takashi Irie, Masaya Fukushi, and Tomoichiro Asano of Hiroshima University; Jeffrey Encinas of Amenis Bioscience, Inc.; and Takayoshi Okabe of The University of Tokyo.
AMED, JST SPRING, and the JSPS Program for Forming Japan’s Peak Research Universities supported this research.
No comments yet